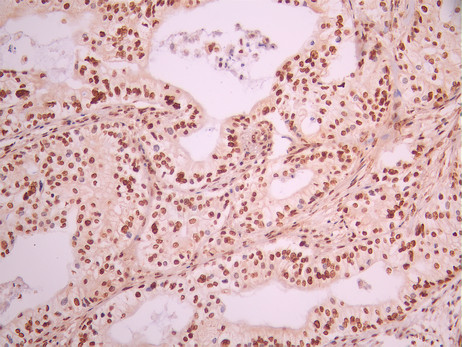

GTF2I Recombinant Monoclonal Antibody
-
中文名稱:GTF2I Recombinant Monoclonal Antibody
-
貨號:CSB-RA208150A0HU
-
規格:¥1320
-
圖片:
-
IHC image of CSB-RA208150A0HU diluted at 1:100 and staining in paraffin-embedded human pancreatic cancer performed on a Leica BondTM system. After dewaxing and hydration, antigen retrieval was mediated by high pressure in a citrate buffer (pH 6.0). Section was blocked with 10% normal goat serum 30min at RT. Then primary antibody (1% BSA) was incubated at 4°C overnight. The primary is detected by a Goat anti-rabbit polymer IgG labeled by HRP and visualized using 0.05% DAB.
-
Immunofluorescence staining of A549 cell with CSB-RA208150A0HU at 1:50 , counter-stained with DAPI. The cells were fixed in 4% formaldehyde, permeabilized using 0.2% Triton X-100 and blocked in 10% normal Goat Serum. The cells were then incubated with the antibody overnight at 4°C. The secondary antibody was Alexa Fluor 488-congugated AffiniPure Goat Anti-Rabbit IgG(H+L).
-
Overlay Peak curve showing SH-SY5Y cells stained with CSB-RA208150A0HU (red line) at 1:100. The cells were fixed in 4% formaldehyde and permeated by 0.2% TritonX-100 for 10min. Then 10% normal goat serum to block non-specific protein-protein interactions followed by the antibody (1ug/1*106cells) for 45min at 4℃. The secondary antibody used was FITC-conjugated goat anti-rabbit IgG (H+L) at 1/200 dilution for 35min at 4℃.Control antibody (green line) was Rabbit IgG (1ug/1*106cells) used under the same conditions. Acquisition of >10, 000 events was performed.
-
-
其他:
產品詳情
-
Uniprot No.:
-
基因名:
-
別名:BAP 135 antibody; BAP-135 antibody; BAP135 antibody; Bruton tyrosine kinase associated protein 135 antibody; Bruton tyrosine kinase-associated protein 135 antibody; BTK associated protein 135 antibody; BTK associated protein 135kD antibody; BTK associated protein antibody; BTK-associated protein 135 antibody; BTKAP 1 antibody; BTKAP1 antibody; DIWS antibody; FLJ38776 antibody; FLJ56355 antibody; General transcription factor II i antibody; General transcription factor II-I antibody; General transcription factor IIi antibody; GTF 2I antibody; Gtf2i antibody; GTF2I_HUMAN antibody; GTFII I antibody; GTFII-I antibody; IB 291 antibody; IB291 antibody; SPIN antibody; SRF Phox 1 interacting protein antibody; SRF Phox1 interacting protein antibody; SRF-Phox1-interacting protein antibody; TFII-I antibody; Transcription factor II I antibody; WBS antibody; WBSCR 6 antibody; WBSCR6 antibody; Williams Beuren syndrome chromosome region 6 antibody; Williams Beuren syndrome chromosome region 6 protein antibody; Williams-Beuren syndrome chromosomal region 6 protein antibody
-
反應種屬:Human
-
免疫原:A synthesized peptide from human GTF2I protein
-
免疫原種屬:Homo sapiens (Human)
-
標記方式:Non-conjugated
-
克隆類型:Monoclonal
-
抗體亞型:Rabbit IgG
-
純化方式:Affinity-chromatography
-
克隆號:13B10
-
濃度:It differs from different batches. Please contact us to confirm it.
-
保存緩沖液:Rabbit IgG in 10mM phosphate buffered saline , pH 7.4, 150mM sodium chloride, 0.05% BSA, 0.02% sodium azide and 50% glycerol.
-
產品提供形式:Liquid
-
應用范圍:ELISA, IHC, IF, FC
-
推薦稀釋比:
Application Recommended Dilution IHC 1:50-1:200 IF 1:50-1:200 FC 1:50-1:200 -
Protocols:
-
儲存條件:Upon receipt, store at -20°C or -80°C. Avoid repeated freeze.
-
貨期:Basically, we can dispatch the products out in 1-3 working days after receiving your orders. Delivery time maybe differs from different purchasing way or location, please kindly consult your local distributors for specific delivery time.
-
用途:For Research Use Only. Not for use in diagnostic or therapeutic procedures.
相關產品
靶點詳情
-
功能:Interacts with the basal transcription machinery by coordinating the formation of a multiprotein complex at the C-FOS promoter, and linking specific signal responsive activator complexes. Promotes the formation of stable high-order complexes of SRF and PHOX1 and interacts cooperatively with PHOX1 to promote serum-inducible transcription of a reporter gene deriven by the C-FOS serum response element (SRE). Acts as a coregulator for USF1 by binding independently two promoter elements, a pyrimidine-rich initiator (Inr) and an upstream E-box. Required for the formation of functional ARID3A DNA-binding complexes and for activation of immunoglobulin heavy-chain transcription upon B-lymphocyte activation.
-
基因功能參考文獻:
- demonstrate a marked prevalence of a thymoma-specific mutated oncogene, GTF2I PMID: 29438696
- we identified largest-ever effect on Asian rheumatoid arthritis across human non-HLA regions at GTF2I by heterogeneity mapping followed by replication studies, and pinpointed a possible causal variant PMID: 27272985
- the frequency of GTF2I mutation is higher in more indolent TETs and correlated with better prognosis. PMID: 28676218
- GTF2I/Gtf2i, its physiologic role in human disorders was relatively unknown until recently. Novel studies show that it is involved in an array of human diseases including neurocognitive disorders, systemic lupus erythematosus (SLE), and cancer. PMID: 28461154
- the results reported here support a model whereby common genetic variation in GTF2I mediates human sociality and anxiety via effects on oxytocin reactivity. PMID: 28424317
- GTF2I mutations common in thymic epithelial tumors are not present/uncommon in hematological malignancies. PMID: 28982856
- a new BRAF fusion in pilocytic astrocytoma PMID: 28448514
- A common polymorphism in the Williams syndrome gene GTF2I associated with reduced social anxiety predicts decreased threat-related amygdala reactivity, which mediates an association between genotype and increased warmth in women. PMID: 26853120
- We identified rs117026326 on GTF2I with GWAS significance (P = 1.10 x 10(-15)) and rs13079920 on RBMS3 with suggestive significance (P = 2.90 x 10(-5)) associating with Primary Sjogren's syndrome in women. PMID: 27503288
- The authors found that human adenovirus 5 infection or ectopic E4-ORF3 expression leads to SUMOylation of TFII-I that precedes a rapid decline in TFII-I protein levels. PMID: 26814176
- A novel interaction between TFII-I and Mdm2 with a negative effect on TFII-I transcriptional activity has been documented. PMID: 26656605
- Copy-number variation in the general transcription factor gene, GTF2I is associated with gene-dose-dependent anxiety in mouse models and in both Williams syndrome and Dup7. PMID: 26285132
- show that SUMOylation is critical for TFII-I to promote cell proliferation and colony formation. Our findings contribute to understanding the role of SUMOylation in liver cancer development PMID: 25869096
- Study demonstrates a significant association between SLE in Chinese Han population and the GTF2I rs117026326 T allele/GTF2IRD1 rs4717901 C allele. PMID: 26320362
- Rather than contributing positively to promoter activity, a putative initiator element at the transcription start site acts as a target for negative regulation imposed on the L4P promoter of human adenovirus Type 5 by cellular TFII-I. PMID: 25926634
- Findings implicate the GTF2I gene in the neurogenetic basis of social communication and social anxiety, both in Williams syndrome and among individuals in healthy populations PMID: 25429715
- TFII-I bridges Proliferating Cell Nuclear Antigen and Polzeta to promote Translesion synthesis PMID: 24922507
- The GTF2I rs117026326 polymorphism is associated with anti-SSA-positive primary Sjogren's syndrome. PMID: 25480810
- A proportion of this transcriptional dysregulation is caused by dosage imbalances in GTF2I, which encodes a key transcription factor at 7q11.23 that is associated with the LSD1 repressive chromatin complex and silences its dosage-sensitive targets. PMID: 25501393
- GTF2I mutation correlated with better survival. PMID: 24974848
- Results reveal novel mechanisms by which TFII-I and DBC1 can modulate cellular fate by affecting cell-cycle control as well as the homologous recombination pathway. PMID: 24231951
- Our findings suggest the GTF2i gene is important in the etiology of autism in individuals with this duplication and in non-duplication cases with severe social interaction problems and repetitive behaviors. PMID: 22048961
- GTF2I duplication results in separation anxiety in mice and humans PMID: 22578324
- CLIP2 haploinsufficiency by itself does not lead to the physical or cognitive characteristics of the Williams-Beuren syndrome; GTF2IRD1 and GTF2I are the main genes causing the cognitive defects PMID: 22608712
- TFII-I gene deletion may explain the Williams-Beuren syndrome phenotype because it acts as a negative regulator of TRPC3 expression in human B lymphocytes. PMID: 22566418
- These data indicate that an E-box motif (RBE1) within the core promoter in the long terminal repeat of HIV-1 is a bona fide binding site for the RBF-2 transcription factor complex USF1, USF2, and TFII-I. PMID: 21813151
- Data demonstrate that not only does cell surface GRP78 regulate apoptosis, but it also regulates Ca(2+) homeostasis by controlling cell surface localization of TFII-I. PMID: 21503958
- Data show that Igh 3' enhancer-bound OCA-B and promoter-bound TFII-I mediate promoter-enhancer interactions, in both cis and trans, that are important for Igh transcription. PMID: 21549311
- These data indicate that Gtf2i is involved in several aspects of embryonic development and the development of social neurocircuitry and that GTF2I haploinsufficiency could be a contributor to the hypersociability in WBS patients. PMID: 21328569
- TFII-I may modulate the cellular functions of BRCA1. PMID: 21407215
- functional hemizygosity for the GTF2I and GTF2IRD1 genes is the main cause of the neurocognitive profile and some aspects of the gestalt phenotype of Williams-Beuren syndrome PMID: 19897463
- G-kinase I beta interacted specifically with TFII-I, an unusual transcriptional regulator that associates with multiple proteins to modulate both basal and signal-induced transcription PMID: 12082086
- GTF2IRD1 and GTF2I have roles in causing deficits on visual spatial functioning PMID: 12865760
- Comparison of these five families with reports of other individuals with partial deletions of the WS region most strongly implicates GTF2I in the mental retardation of WS. PMID: 14556246
- TFII-I is required for optimal induction of Grp78 by ER stress PMID: 15664986
- These results demonstrate that USF1/USF2 and TFII-I interact cooperatively at the upstream RBEIII element and are necessary for the induction of latent HIV-1 in response to T-cell activation signals. PMID: 15767439
- human VEGFR-2 promoter is functionally counter-regulated by TFII-I and TFII-IRD1. PMID: 15941713
- cGMP-dependent protein kinase Ibeta binds to TFII-I and IRAG through a common interaction motif PMID: 16166082
- TFII-I is recruited to the cyclin D1 promoter and transcriptionally activates this gene. PMID: 16314517
- TFII-I directly interacts with Bright through amino acids in Bright's protein interaction domain PMID: 16738337
- The data suggest that TFII-I and USF regulate chromatin structure accessibility and recruitment of transcription complexes in the beta-globin gene locus. PMID: 16943425
- observations suggest a model in which TFII-I suppresses agonist-induced calcium entry by competing with TRPC3 for binding to phospholipase C-gamma PMID: 17023658
- TFII-I, PARP1, and SFPQ proteins, each previously implicated in gene regulation, form a complex controlling transcription of DYX1C1. Allelic differences in the promoter or 5'UTR of DYX1C1 may affect factor binding and thus regulation of the gene. PMID: 18445785
- Bioinformatics and microarray results were combined to identify TFII-I downstream targets in the vertebrate genome. PMID: 18579769
- These results demonstrate an essential role of TFII-I bound at an upstream LTR element for viral replication. PMID: 18976654
- alpha(2)-macroglobulin induced increase in GRP78 synthesis is caused by transcriptional upregulation of TFII-I PMID: 19097122
- analyzed promoter regions of TFII-I genes and described their additional exons, as well as tested tissue specificity of both previously reported and novel alternatively spliced isoforms PMID: 19111598
- Results suggest that TFII-I appears to have distinct roles in distinct phases of the mammalian cell cycle. PMID: 19182516
- these results provide an initial step in understanding the biological role of Itk-TFII-I signaling in T-cell function. PMID: 19701889
- TFII-I plays an inhibitory role in regulating genes that are essential in osteogenesis and intersects with the bone-specific transcription factor Runx2 and the retinoblastoma protein, pRb. PMID: 19880526
顯示更多
收起更多
-
相關疾病:GTF2I is located in the Williams-Beuren syndrome (WBS) critical region. WBS results from a hemizygous deletion of several genes on chromosome 7q11.23, thought to arise as a consequence of unequal crossing over between highly homologous low-copy repeat sequences flanking the deleted region. Haploinsufficiency of GTF2I may be the cause of certain cardiovascular and musculo-skeletal abnormalities observed in the disease.
-
亞細胞定位:Cytoplasm. Nucleus. Note=Colocalizes with BTK in the cytoplasm.
-
蛋白家族:TFII-I family
-
組織特異性:Ubiquitous. Isoform 1 is strongly expressed in fetal brain, weakly in adult brain, muscle, and lymphoblasts and is almost undetectable in other adult tissues, while the other isoforms are equally expressed in all adult tissues.
-
數據庫鏈接:
Most popular with customers
-
-
YWHAB Recombinant Monoclonal Antibody
Applications: ELISA, WB, IHC, IF, FC
Species Reactivity: Human, Mouse, Rat
-
Phospho-YAP1 (S127) Recombinant Monoclonal Antibody
Applications: ELISA, WB, IHC
Species Reactivity: Human
-
-
-
-
-